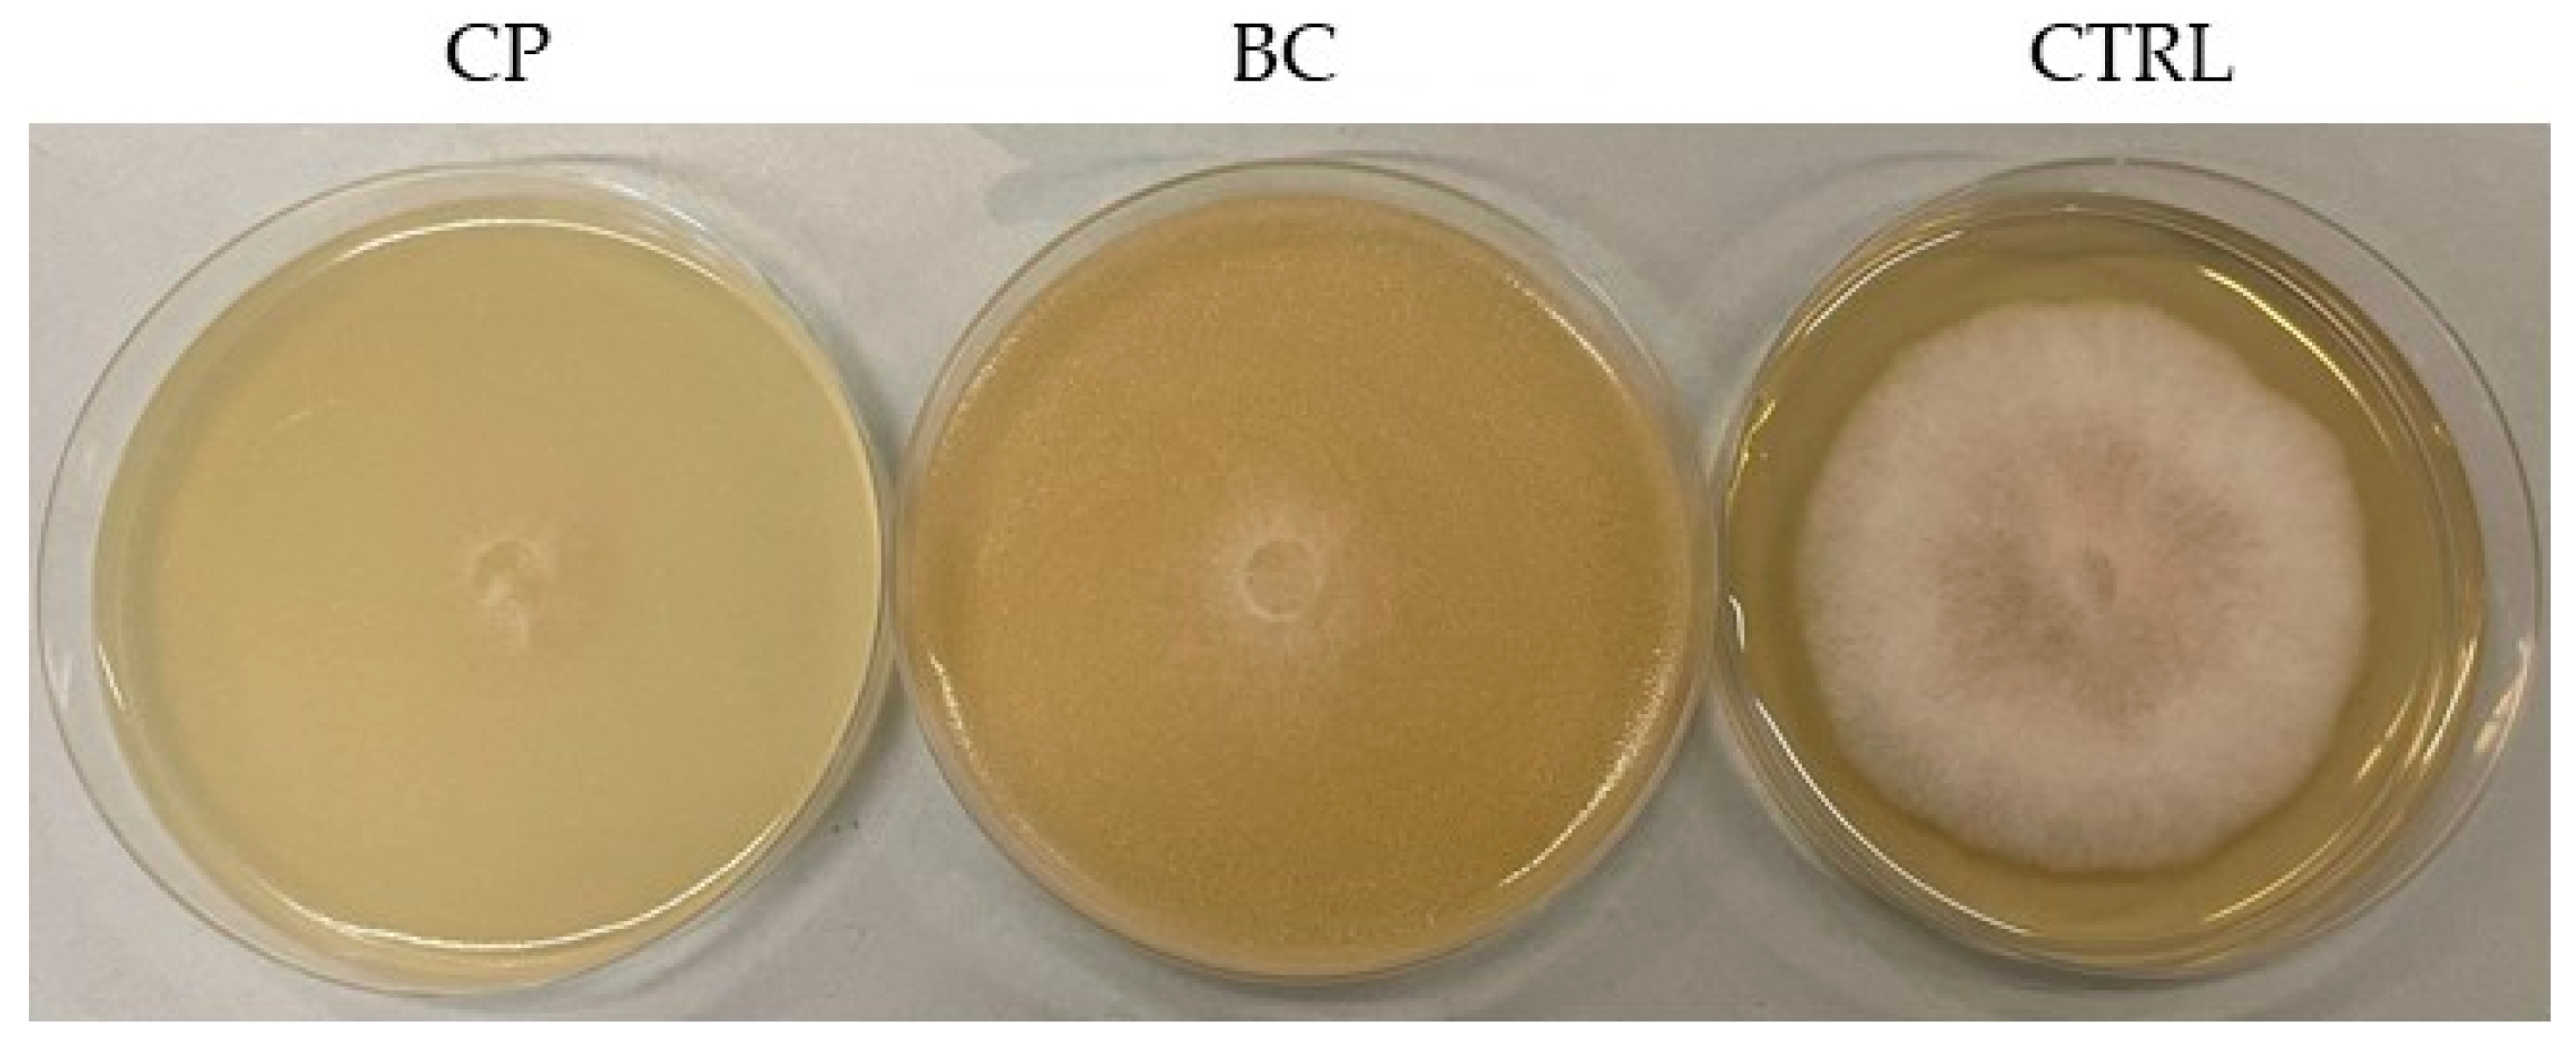
Jof 11 00336 g006

Abstract
Chalkbrood is the manifestation of the fungal disease caused by Ascosphaera apis, which affects broods of developing honeybees, particularly in Apis mellifera colonies. Recently, Metschnikowia pulcherrima has been proposed as a biocontrol agent in winemaking and for the management of major postharvest and soil-borne plant pathogenic fungi. In this study, the antagonistic activity of three M. pulcherrima strains against fifteen A. apis strains, isolated from contaminated hives of A. mellifera, was evaluated, with a specific focus on the potential antifungal activity of volatile organic compounds (VOCs). The study revealed that M. pulcherrima was effective against A. apis and that the antifungal activity was related to various mechanisms including competition for nutrients, secretion of pulcherriminic acid, and biosynthesis of specific antifungal VOCs. We also found that each M. pulcherrima strain produced a unique combination of VOCs, and the antifungal activity was strain-dependent and varied depending on the specific yeast-mold combination. In addition, preliminary analyses showed that a temperature of 30 °C and a higher amount of glucose (40 g/L) in the growing medium promote the growth of A. apis. These results could be useful for designing new strategies for the biocontrol of chalkbrood disease in honeybee colonies.
1. Introduction
Pollination is an ecosystem function considered fundamental to plant reproduction, agricultural production, and the maintenance of terrestrial biodiversity [1,2].
A loss of pollinators may have negative impacts on the reproduction of wild plants, as more than 90% of tropical flowering plant species and about 78% of temperate-zone species rely, at least in part, on animal pollination [3]. The potential risks associated with pollinators’ decline have led to a surge in research aimed at understanding the factors and interactions that are crucial to developing targeted responses to this pressing issue [4,5]. There are over 20,000 species of bees worldwide, which represent the dominant pollinators in most ecosystems. Specifically, the western honeybee, Apis mellifera, is the most ubiquitous managed crop pollinator worldwide [6].
In the past five decades, there has been a documented decrease in the biodiversity of wild bees and other pollinators [7]. The factors deemed responsible for this decline include land-use change and intensity, climate change, pesticides, and the transfer of pathogens and diseases [8]. Recent studies have demonstrated that stress factors do not act in isolation but rather synergistically and that their interactions can be difficult to predict [9]. While pathogens and diseases primarily threaten managed European honeybees [10], the decline in wild bees seems to be particularly related to land use change and agricultural intensification [11,12,13,14].
A honeybee colony can host a diverse range of pathogens, including bacteria, fungi, viruses, parasitic mites, and even insects that aim to exploit the abundant resources within the hives, which contributes to colony decline [1,15,16]. Chalkbrood, caused by the fungus Ascosphaera apis, is the common name for a fungal disease that weakens developing broods and impacts various bee taxa, particularly A. mellifera colonies [17,18,19,20]. Recent evidence suggests that the incidence of this disease is globally on the rise [21,22,23,24], probably attributable to the wide distribution of A. apis and the prolonged viability of its spores [25]. Recent research shows that chalkbrood makes honeybees more vulnerable to other pests and diseases, such as viruses that might infect and replicate within A. apis [26,27,28]. Clinical outbreaks of chalkbrood are primarily caused by environmental factors, the colony’s health status, genetic predispositions, and the stress factors affecting the brood at the time of infection [29,30]. The initial phase of infection can be facilitated by nutritional or environmental stressors that disrupt the composition of the gut microbiota [31]. Khan et al. [32] suggested that a decline in culturable aerobic gut bacteria in nurse bees serves as a prognostic marker for chalkbrood outbreaks. In this context, bacteria from the bee gut that inhibit chalkbrood have been proposed as potential probiotics for controlling chalkbrood and other fungal diseases in bees [32,33,34]. Honeybee larvae aged 1 to 4 days are particularly susceptible to fungal infection by A. apis, which is primarily transmitted through contaminated food provided by nurse bees. Infection occurs when larvae ingest ascospores orally, leading to spore germination in the posterior midgut. The fungal hyphae invade the epithelial cells and basal membrane of the midgut, with the mycelium then progressing into the hemocoel and eventually penetrating all organs, causing larval death by day 3 [35]. Over the past years, a wide range of chemotherapeutic compounds have been tested against A. apis [29,33], but none have proven effective in preventing the disease. The human health risks associated with pesticide and antifungal residues in honey have driven growing interest in natural compounds as alternative control strategies [36,37,38,39,40,41].
The use of microbial resources for the prevention and biocontrol of honeybee pathogens, including chalkbrood disease, presents promising possibilities [42,43,44]. Iorizzo et al. [33] demonstrated that Apilactobacillus kunkeei (formerly Lactobacillus kunkeei) and Lactiplantibacillus plantarum [34] inhibit the mycelial development of A. apis in vitro. These bacteria may help restore gut symbiosis and prevent A. apis infection. Additionally, studies indicate that beneficial bacteria isolated from the bee gut and hive products show potential as probiotics for controlling chalkbrood disease [21,43,45]. Over the past decade, researchers have increasingly focused on the role of the honeybee gut microbiome, investigating its specific microbial components [46,47,48,49]. While most studies on insect-associated microbiota have concentrated on bacteria, other microbial partners, such as fungi, have been largely overlooked. Insects frequently host microbial symbionts, with insect-fungal associations playing key roles in nutrition and defense [50]. Within the gastrointestinal tract of the insects, including honeybees, there is also an eukaryotic portion represented by yeast species [51,52,53]. Yeasts have been identified in at least 143 insect species across various orders, indicating their widespread and diverse associations with insects [52,54]. Although symbiotic relationships between hymenopterans and fungi have been documented, and yeasts are known to be abundant in bee bread and nectar, the honeybee mycobiome and its impact on host fitness remain largely unexplored. Recently, probiotics—particularly lactic acid bacteria (LAB) and select yeasts—have gained attention as promising alternatives to antibiotics for managing bee diseases [43,44,55,56]. The most commonly found yeast genera in the honeybee gastrointestinal tract and its agro-ecosystem (including bee bread, propolis, and pollen) include Candida, Debaryomyces, Metschnikowia, Meyerozyma, Pichia, Starmerella, and Zygosaccharomyces [55,56,57]. Most Metschnikowia species (and anamorphs) are terrestrial and form diverse mutualistic symbioses that include a multitude of associations, especially with angiosperms and their associated insects [58]. The strong antagonistic properties of M. pulcherrima have sparked research into its ecological roles, yet a comprehensive understanding of its interactions and their modulation by environmental factors remains limited [59]. Recently, M. pulcherrima has gained interest as a potential probiotic yeast for animal and human feed [55,60,61,62,63,64,65]. Although the nature of the association between Metschnikowia species and insects is not fully understood, evidence suggests that these relationships can be highly specific [66]. Due to its strong antimicrobial activity and the absence of toxic byproducts, M. pulcherrima has been the focus of several technological innovations. Over the past decade, multiple patents have been filed concerning its applications [67,68], and numerous M. pulcherrima strains have been proposed as biocontrol agents in winemaking, cheese production, and the management of major postharvest and soil-borne plant pathogenic fungi [69,70,71,72,73,74,75,76,77,78,79,80,81,82].
The antimicrobial activity of M. pulcherrima is mediated by multiple mechanisms, including iron depletion through pulcherrimin production, competition for nutrients, secretion of extracellular lytic enzymes (e.g., chitinase and glucanase), biofilm formation, and the release of volatile organic compounds (VOCs) [67,77]. In particular, previous studies have shown that among the main VOCs released by M. pulcherrima, ethyl acetate and 2-phenylethanol are effective in postharvest preservation of strawberries and blueberries [71,83].
To date, no scientific studies have explored the use of M. pulcherrima against pathogenic honeybee fungi, particularly A. apis. Therefore, this study aimed to assess the antagonistic activity of three previously isolated and characterized M. pulcherrima strains [84,85,86] against fifteen A. apis strains obtained from contaminated hives. Antimicrobial tests were conducted using different cultural matrices of the three mentioned yeasts, with a specific focus on evaluating the antifungal efficacy of VOCs produced by them.
2. Materials and Methods
2.1. Yeast Cultures
M. pulcherrima 62, M. pulcherrima 86, and M. pulcherrima AS3C1 (GenBank accession numbers: PP922572.1, PP922571.1, OM038321) were obtained from the culture collection of the Di.A.A.A. (Department of Agricultural, Environmental, and Food Sciences, University of Molise, Campobasso, Italy).
2.2. Isolation of Ascosphaera apis
In A. mellifera colonies, the presence of mummified larvae in the brood comb, lower hive table, and hive entrance has been considered a common sign of chalkbrood disease. The fungal strains used in this study were isolated from fresh white mummies collected during the springs of 2022 and 2023 from brood frames, bottom boards, or hive entrances in the Campania and Molise regions of Southern Italy.
Following the method described by Jensen et al. [87], the collected mummies were surface-sterilized in 10% sodium hypochlorite for 10 min and then rinsed with sterile distilled water for 2 min under aseptic conditions. The mummies were subsequently dissected into smaller fragments and placed on Sabouraud Dextrose Agar (SDA) plates [87]. Once mycelial growth became visible around the inoculated samples, incubated at 30 °C for 3–4 days, actively growing fungal tips were transferred onto fresh SDA plates. The purification of A. apis was achieved through three rounds of subculturing of hyphal tips on SDA according to the methods described by Jensen et al. [87]. All strains have the same morphological characteristics. By way of representation, Figure 1 shows some morphological details of the colony and mycelial hyphae of A. apis CB3 on SDA.
Figure 1.
Morphological characters of the colony ((A) front; (B) back) and mycelial hyphae ((C) 100×, (D) 200×) of A. apis CB3 on SDA.
2.3. Genotypic Identification
Molecular identification of the fungal cultures was conducted through sequencing and analysis of the internal transcribed spacer (ITS) region of nuclear rDNA. Genomic DNA was extracted from the mold strains using Fungi/Yeast Genomic DNA Isolation Kits (Norgen Biotek, Thorold, ON, Canada), following the manufacturer’s instructions.
The full ITS region was amplified using the universal primers ITS1 (5′-TCC GTA GGT GAA CCT GCG G-3′) and ITS4 (5′-TCC TCC GCT TAT TGA TAT GC-3′) [88]. The polymerase chain reaction (PCR) mixture consisted of 10 μL of 2× PCR master mix (Norgen Biotek), 2 μL of each primer (2.5 μM), 4 μL of Milli-Q water, and 2 μL of template DNA. For the negative control, Milli-Q water was used as a substitute for the DNA template. PCR reactions were conducted using a Mastercycler Nexus PCR thermal cycler (Eppendorf, Hamburg, Germany). The amplification process followed a thermal cycling program consisting of an initial denaturation at 95 °C for 10 min, followed by 35 cycles of denaturation at 95 °C for 30 s, annealing for 1 min, and extension at 72 °C for 1 min. A final extension step was performed at 72 °C for 5 min. The PCR products were analyzed using electrophoresis on a 1.0% (w/v) agarose gel in a 1× Tris-acetate–EDTA (TAE) buffer. The amplified DNA was visualized under a UV transilluminator (Bio-Rad, Hercules, CA, USA), and fragment sizes were estimated by comparison with a 1 kb DNA ladder (Norgen Biotek). The PCR products were purified using a QIAquick PCR purification kit (QIAGEN GmbH, Hilden, Germany) and subsequently sent to an external sequencing service (Eurofins MWG Biotech Company, Ebersberg, Germany). The resulting sequences were analyzed using the Basic Local Alignment Search Tool (BLASTN) program [89] and compared with reference data available in the National Center for Biotechnology Information (NCBI) database [90]. A sequence alignment of 99–100% similarity was considered the criterion for taxonomic identification at the species level [91].
A phylogenetic tree was inferred using the ITS sequences of the fifteen A. apis strains with the maximum likelihood method. Genetic distances were calculated based on the Kimura 2 parameter model [92] by applying 1000 replicates. Evolutionary rate differences among sites were modeled using a discrete gamma distribution (5 categories, +G, parameter = 0.2275). Evolutionary analyses were performed in MEGA11 [93].
2.4. Growth Parameters of A. apis
Three culture media, potato dextrose agar (PDA), Sabouraud dextrose agar (SDA), and malt extract agar (MEA), were used for fungal growth experiments (Thermo Fisher Scientific, Waltham, MA, USA).
Three-day-old cultures of each A. apis strain were used for the tests. A single disk, excised from the edge of actively growing mycelium, was placed at the center of each Petri dish (90 mm) containing the respective medium. All plates were incubated at three different temperatures (25.0 ± 1.0 °C, 30.0 ± 1.0 °C, and 35.0 ± 1.0 °C), with relative humidity (RH) maintained at approximately 60%. After six days of incubation, the mycelial growth was assessed by measuring the colony diameter (mm) using a caliper.
2.5. Antifungal Activity
Different methods were used to investigate the antifungal activity of M. pulcherrima against A. apis.
2.5.1. Preliminary Antifungal Screening
The antifungal activity of M. pulcherrima against A. apis was assessed following the protocol described by Iorizzo et al. [33] utilizing three distinct matrices: broth culture (BC), cell-free supernatants (CFS), and cell pellet (CP). To obtain these fractions, M. pulcherrima was cultured in yeast peptone dextrose (YPD) broth (Thermo Fisher Scientific) and incubated at 30 °C for 48 h, achieving a final cell concentration of 10⁸ CFU/mL. The untreated yeast culture served as the BC matrix. To prepare the CFS fraction, 5 mL of the yeast culture were centrifuged at 8000 rpm for 15 min at 4 °C, and the resulting supernatant was sterilized via filtration using a 0.22 μm pore-size cellulose acetate filter. The CP fraction was obtained by washing the residual cell pellet and resuspending it in 5 mL of sterile distilled water. Antifungal assays were performed by inoculating single mycelial discs (6 mm in diameter) of A. apis, pre-cultured on SDA for three days at 30 °C, into the center of 90 mm Petri dishes containing the SDA medium. Each plate was supplemented with 5 mL of one of the M. pulcherrima matrices (BC, CFS, or CP). A control test was also included, consisting of an A. apis mycelial disc on SDA without yeast-derived matrices. All plates were incubated at 30 °C under aerobic conditions, with three biological replicates per yeast-fungus combination. After six days of incubation, the radial growth of A. apis mycelium was measured using a digital caliper and compared against the control test. The inhibition of radial growth (% I) was determined using the equation % I = (C − T/C) × 100 [94], where % I represents the percent inhibition of radial mycelium growth, C is the radial growth measurement in the control test, and T corresponds to the radial growth of A. apis in the presence of M. pulcherrima matrices (BC, CFS, and CP).
2.5.2. Evaluation of the Antifungal Activity of M. pulcherrima VOCs
The inhibitory effect of volatile organic compounds (VOCs) produced by M. pulcherrima against A. apis was assessed using a double-dish system (DDS), following the methodology described by Ruiz-Moyano et al. [95] with modifications (Figure 2). A 100 μL aliquot of a 48 h M. pulcherrima culture, standardized to 1 × 10⁸ cells/mL in YPD broth, was evenly spread onto YPD agar plates (90 mm). Concurrently, a single A. apis mycelial disc (6 mm in diameter), pre-cultured on SDA for three days at 30 °C, was placed at the center of an SDA plate. The lids of both plates were removed, and the two dishes were sealed together using Parafilm (Pechiney Plastic Packaging Company Milwaukee, WI, USA) to create a closed DDS chamber. The system was incubated at 30 °C, with the A. apis-inoculated plate positioned at the bottom. Fungal radial growth was measured daily using a digital caliper. The control consisted of a DDS setup containing only A. apis. After six days of incubation, radial growth inhibition was calculated using the previously described formula. Each yeast-fungus combination was tested in triplicate.
Figure 2.
Experimental workflow for the double-dishes system (DDS) used to evaluate the antifungal activity of M. pulcherrima volatile organic compounds (VOCs). Phase 1: M. pulcherrima was cultured on YPD agar medium, while A. apis was grown on SDA medium under standard incubation conditions. Phase 2: The two Petri dishes were sealed with Parafilm, positioned face-to-face to establish the DDS, and incubated for 4 days to allow VOC emission; VOCs were subsequently captured using a solid-phase microextraction (SPME) fiber. Phase 3: VOCs were analyzed using gas chromatography coupled with mass spectrometry (GC-MS) for qualitative and quantitative profiling (created with BioRender.com, https://app.biorender.com/illustrations/67c1d80f4c97b8e297f2f262, accessed on 10 March 2025).
2.6. Identification of Volatile Organic Compounds (VOCs)
Antifungal VOCs were identified using M. pulcherrima strains AS3C1, 86, and 62 as producer strains, with A. apis CB3 serving as the target fungal strain. All tests were conducted in triplicate.
2.6.1. Volatile Compounds Extraction
VOCs were extracted by headspace solid-phase microextraction (HS-SPME). According to Ruiz-Moyano et al. [95], to sample the VOCs, the double-dish system (Figure 1) was previously incubated at 40 °C for 15 min in an oven. Successively, a DVB/CAR/PDMS fiber (50/30 mm, 2 cm) was introduced into the space of the double-dish system for 30 min at 40 °C and then inserted into the GC injector to allow the VOCs’ desorption at 240 °C for 10 min. Volatile compounds were determined by extraction and analyses of control DDS without yeast inoculation. Blank runs were also run to avoid possible volatile contamination during the analysis.
2.6.2. Gas Chromatography/Mass Spectrometry (GC/MS) Analysis
The VOCs were analyzed by an Agilent 7890A gas chromatographer (7890A, Agilent Technologies, Santa Clara, CA, USA) hyphenated to a 5975A mass spectrometer (5975A, Agilent Technology, Santa Clara, CA, USA) and equipped with a capillary column HP-Innowax (30 m × 0.25 mm × 0.5 µm). Analyses were performed as described by Serradilla et al. [96]. In particular, the oven temperature was initially set at 40 °C for 3 min, followed by a temperature increase to 150 °C at a ramp rate of 4 °C/min holding for 1 min and a second increase to 150 °C at a ramp rate of 3 °C/min, holding the final temperature for 2 min. Helium, at a flow rate of 1 mL/min, was the carrier gas. The temperatures of the ion source and quadrupole were 230 °C and 150 °C, respectively. Mass spectra were carried out in electronic impact (EI) mode at 70 eV, using the splitless mode and in the range of m/z 30–300.
The mass spectra libraries Nist05 and Wiley07 and the linear retention indices (LRI) were used for VOCs identification. Moreover, the identity of certain compounds was confirmed by using commercial standards analyzed under the same conditions. Semi-quantitative data of each volatile metabolite (relative peak area, RPA%) were measured as a ratio for the peak area of 3-octanol used as an internal standard (IS). Areas of the identified VOCs were obtained from the total ion chromatogram (TIC).
2.7. Statistical Analysis
The preliminary antifungal and antifungal activity of M. pulcherrima VOCs was evaluated through statistical analysis conducted in RStudio (R version 4.3.0). Data from three independent experiments were expressed as mean ± standard deviation (SD) and analyzed using ANOVA with Tukey’s post hoc tests. Statistical significance was attributed to p-values < 0.05. Additionally, VOC data were analyzed via principal component analysis (PCA) using the FactoMineR and factoextra packages (version 4.2.2) for data processing and visualization.
3. Results and Discussions
3.1. Taxonomical Identification
The utilization of Sanger sequencing of the internal transcribed spacer (ITS) allowed for the identification of the 15 isolates as A. apis. The GenBank accession numbers for the sequences are provided in Table S1 (Supplementary Materials). The resulting phylogenetic tree (Figure 3) demonstrated that the isolates constituted a monophyletic group, suggesting the presence of a shared progenitor among the strains [97]. The percentages above the tree branches represent the site coverage. The presence of subclusters signifies the existence of genetic diversity, which can be attributed to either environmental adaptation, geographical origins, or host interaction. Some strains exhibited greater kinship, suggesting recent divergence, whereas others demonstrated a higher degree of genetic distance. Aspergillus niger was included as an outgroup alongside the A. apis type strain (CBS 534.69) to root the phylogenetic tree and emphasize the evolutionary divergence between A. apis and the fungal isolates.
Figure 3.
Phylogenetic tree based on the ITS sequences of the fifteen A. apis strains using the maximum likelihood method. The genetic distances were calculated based on the Kimura 2-parameter model by applying 1000 replicates.
3.2. Growth Parameters of the A. apis
Following taxonomic identification, a series of growth assays were performed under varying temperature conditions and across different agarized media. The data shown in Figure 4 reveal a clear trend in which temperature and culture media composition significantly influence fungal growth dynamics. Across all tested conditions, 30 °C appears to be the optimal temperature, supporting the highest radial expansion in all media. Growth at 20 °C and 37 °C is generally reduced. In the growth evaluation test on different culture media, A. apis strains exhibited more abundant radial mycelial growth on SDA, which contained a higher glucose concentration (40 g/L), compared to the other media used (Supplementary Materials Table S2), after five days. In Figure 3, it is possible to observe the radial mycelia growth of the fifteen A. apis strains as a function of temperature and culture medium used.
Figure 4.
Mean radial growth (mm) after five days of the fifteen A. apis strains on different culture media (MEA, PDA, SDA) at 20 °C, 30 °C, and 35 °C. Error bars indicate the standard deviation (SD) of the mean. Lower case letters indicate statistical difference (p < 0.05).
Our study confirms that media composition, particularly sugar content, critically influences the growth and development of A. apis [98,99]. Conversely, media high in fat or nitrogen content do not support the optimal proliferation of the pathogen [100]. The optimal growth temperature for the isolates was determined to be 30 °C, a finding that is consistently supported by the literature [98,100,101]. Honeybee colonies function as “superorganisms”, with individuals collaborating to ensure colony reproduction, particularly through social cooperation in thermal homeostasis, maintaining rapid and consistent brood development [102]. Thermal homeostasis is crucial for the colony, as honeybee larvae and pupae are highly stenothermic. Maintaining a brood nest temperature of 32–36 °C ensures rapid and consistent developmental rates [102]. A. apis is an opportunistic pathogen that infects and kills larvae only under predisposing conditions, with chalkbrood disease being more prevalent in damp weather and fluctuating temperatures [98].
In the context of colony dynamics, robust colonies capable of maintaining stable internal hive temperatures may better mitigate fungal proliferation. In contrast, weaker colonies struggling with thermoregulation will likely experience a more pronounced fungal spread. Flores et al. [103] demonstrated in a laboratory-scale study that maintaining a hive temperature of 35 °C correlates with a reduced infection rate. This may be explained by the fact that temperatures lower than the optimum can impair vital physiological processes, negatively impacting brood development and rendering the colony more susceptible to pathogen invasion [104,105].
3.3. Preliminary Antifungal Screening and Evaluation of the Antifungal Activity of M. pulcherrima VOCs
The preliminary evaluation of the antimicrobial activity of the three matrices (BC, CP, and CFS) obtained from the three yeasts against the 15 molds showed varying levels of intensity depending on the matrix and the yeast strain. The CP and CFS matrices caused 100% and 0% inhibition for all tested molds and yeasts.
In the case of BC matrices, however, the percentage inhibition varied depending on the yeast-mold combination (Figure 5; Supplementary Table S3). On average, the BC with the highest inhibitory efficacy was that of strain AS3C1 (83.3%), followed by strains 62 and 86. The broth culture of yeast AS3C1 showed the highest inhibition against isolates 1B3R (1), 1A2R 1.2, 1A3R 1.1, AA and 1A3R (2), with inhibition percentages ranging from 91.5% to 100%. Conversely, the isolates that exhibited the lowest inhibition by the broth culture were 1A1R 2.2 (62.5%) and CB4 (63.2%). For the BC of strain 86, its efficacy was highest against mold CB2 (89.2%), while the least inhibited mold was CB3, with an inhibition percentage of 57.2%. The yeast strain 62 showed an inhibition percentage ranging between 90.4% and 67.5%, with the highest recorded for strain 1A3R (2) and the lowest for CB4. Figure 6, by way of example, shows the inhibitory effect against A. apis CB2 by the CP and BC matrices of M. pulcherrima 86.
Figure 5.
Heatmap showing the inhibition (%), after six days on SDA medium against fifteen A. apis strains caused by broth cultures (BC) of M. pulcherrima AS3C1, 86, 62.
Figure 6.
Inhibitory effect of CP and BC matrices of M. pulcherrima 86 on the mycelial growth of A. apis CB2 (CP: cell pellet, BC: broth culture, CTRL: control).
The results of the inhibitory activity exhibited by the VOCs produced by M. pulcherrima are presented graphically in Figure 7 and numerically in Supplementary Table S4. The VOCs with the highest average inhibitory effect were those made by yeast AS3C1 (47.5%), followed by yeasts 86 (44.6%) and 62 (41.1%). Regarding the volatile compounds produced by AS3C1, radial inhibition ranged from 33.2% (1A2R 1.2) to 70.3% (1B2R 2.1). Regarding the VOCs produced by yeast 62, the most inhibited molds were CB2 (72.3%), 1A1R 2.2 (68.6%), and 1A3R 1.1 (65.9%). In contrast, yeast 86 induced inhibitions of 52.2%, 51.8%, and 51.1% against molds 1A1R 1.1, CB4, and 1B2R 2.2, respectively. The findings indicate that the antifungal activity of the VOCs produced by the yeasts is not uniform but varies according to the specific yeast–mold combination.
Figure 7.
Heatmap showing the percentage inhibition after six days of the fifteen A. apis strains caused by the VOCs produced by M. pulcherrima AS3C1, 86, and 62 using double-dishes system (DDS).
Despite the extensive literature on the utilization of Metschnikowia yeasts as bio-control agents (BCA) against postharvest pathogens, there is no evidence supporting the employment of these yeasts in the management of A. apis. The yeasts used in this experiment had been previously characterized for their ability to produce pulcherrimin [84,85]. Pulcherriminic acid is a secondary metabolite naturally produced by several microorganisms, most notably M. pulcherrima, which is able to chelate iron ions through a non-enzymatic reaction to form the extracellular red pigment pulcherrimin. The production of this insoluble compound results in the depletion of iron from the environment, making it unavailable for other microorganisms that need it for their growth [67,68,74,106]. The antifungal activity observed in our study can also be attributed to this mechanism [69,107]. In a study by Sipiczki [67], two M. pulcherrima isolates were tested for their biocontrol against various fungi, including Botrytis cinerea, revealing that strains with lower pulcherrimin production exhibited reduced biocontrol activity. Oro et al. [70] further demonstrated the efficacy of M. pulcherrima Disva 267 for the biocontrol of postharvest brown rot of sweet cherries. According to Settier-Ramírez et al. [72], the use of M. pulcherrima Y29M has proven effective for post-harvest control of Penicillium expansum on apples. Additional antimicrobial mechanisms of M. pulcherrima include nutrient competition, biofilm production, and the production of lytic enzymes such as chitinase, like other microorganisms, including lactic acid bacteria [108,109,110,111,112,113]. In a study conducted by Lombardo et al. [73], M. pulcherrima MPR3 demonstrated strong biocontrol efficacy against B. cinerea and Erysiphe necator on table grapes, with antifungal activity attributed to nutrient and space competition, as well as pulcherrimin production.
3.4. Identification of Antifungal Volatile Organic Compounds (VOCs)
According to several studies, VOCs produced by some microorganisms play a crucial role in inhibiting pathogens, particularly those responsible for post-harvest diseases [109,114]. The variability in the efficacy of different VOCs may be influenced by the specific fungal target. The application of VOCs produced by yeasts, including M. pulcherrima, has been extensively studied in the biological control of post-harvest plant pathogenic fungi [115,116,117]. However, there are no reports of specific VOCs, produced by yeasts, for A. apis inhibition. The analytical method used made it possible to detect a total of 33 VOCs. Each M. pulcherrima strain produced a unique combination of VOCs (Table S5, Supplementary Material). While some compounds were produced by all strains, other compounds were strain specific. The results of PCA (Figure 8) showed that the first two principal components (Dim1 and Dim2) displayed about 86% of the variance.
Figure 8.
Principal component analysis (PCA) reporting the projection of the samples along the first two principal components (Dim1 and Dim2).
Dim1, which accounted for 47.8% of the variance, effectively separated samples 86 and AS3C1 from samples 62 and Aapis_Ctr. Dim2 further distinguished sample 62 from the control (Aapis_Ctr). VOCs mainly responsible for the variation along Dim1 included ethanol, 2-ethylhexanol, 2-butanone, butanoic acid, acetone, 2-furanmethanol, limonene, benzaldehyde, 2-acetylfuran, ethyl acetate, 2,5-dimethylpyrazine, 3-methylbutyl acetate, and ethyl propanoate. Notably, ethanol, ethyl acetate, ethyl propanoate, and 3-methylbutyl acetate were positively associated with Dim1 and with samples 86 and AS3C1 (Figure 9). In contrast, sample 62 was positively correlated with 2-methylbutanal, 3-methylbutanal, isobutyl isothiocyanate, 3-methylbutanoic acid, and 2-methylbutanoic acid, while the control sample (Aapis_Ctr) correlated with 3-methylthiopropanal, dimethyl disulfide, ethyl benzene, toluene, and furfural.
Figure 9.
Biplot-PCA reporting the projection of volatile compounds (VOCs) and samples along the first two principal components (Dim1 and Dim2).
Yeasts exhibit antifungal properties through various mechanisms, including the enhancement of host defenses, competition for nutrients, and the production of antifungal VOCs [118]. Microbial VOCs, which result from various metabolic pathways during the growth of fungi and bacteria, are characterized by low molecular weight (<300 Da) and high vapor pressure (≥0.01 kPa at 20 °C), which is why they evaporate and diffuse easily, making them ideal candidates for agricultural biocontrol applications [71,119,120,121,122]. The capacity of these compounds to exert antimicrobial activity in the absence of direct contact with pathogens is indicative of their potential utility [123]. Referring to this peculiarity, Parafati et al. [124] proposed the use of hydrogel spheres as supports for VOC-producing biocontrol yeasts, opening new avenues for bio-emitters in postharvest packaging.
However, the composition and antifungal properties of volatiles produced by microorganisms are influenced by several environmental and biological factors, including the growth medium, oxygen availability, moisture, temperature, pH, population dynamics, and functional interactions [125]. Among VOCs, esters and alcohols possess antifungal properties and are considered toxic to fungi [116,125]. Antifungal activity of VOCs has been reported to be associated with their functional group [126], and the main mechanism underlying the antifungal effects is the alteration of cell wall and membrane structures, leading to intracellular lysate leakage and oxidative stress induction [118,126,127]. Notably, a mixture of ethanol, 2-methyl-1-propanol, 3-methyl-1-butanol, and 2-phenylethanol altered cell wall structures and resulted in electrolyte leakage in both B. cinerea and A. alternata [128].
Our findings show that all three M. pulcherrima strains produce ethyl acetate, phenylethyl alcohol (2-phenylethanol), 2-methyl-1-propanol, and 3-methyl-1-propanol. Ethyl acetate, synthesized through the reaction of acetic acid with ethanol by yeasts including M. pulcherrima, can inhibit the growth of various fruit fungal pathogens and is therefore effective for post-harvest disease management [71,129]. Prior studies have demonstrated that VOCs as alcohols (ethyl alcohol, 3-methyl-1-butanol, and phenylethyl alcohol) and esters (ethyl acetate and isoamyl acetate) produced by Wickerhamomyces anomalus, M. pulcherrima, Aureobasidium pullulans, and Saccharomyces cerevisiae effectively inhibited postharvest fruit pathogens [123,130,131]. Research by Li et al. [83] highlighted that M. pulcherrima T-2 produced several VOCs with antifungal activity against B. cinerea, including benzyl alcohol, phenylethyl alcohol, benzaldehyde, 2-ethyl-1-hexanol, acetic acid, octanoic acid, 3-hydroxy-2-butanone, 2,5-dimethylpyrazine, and isoamyl acetate. Among these, 2-phenylethanol exhibited strong antifungal activity, with its mechanism attributed to ROS stress induction and cell membrane alteration [132,133]. Some of the VOCs known to have antifungal activity against plant pathogens include organic acids such as 3-methylbutanoic acid [118], which our tests showed was produced by M. pulcherrima 62.
M. pulcherrima AS3C1 compared with the other two strains, M. pulcherrima 62 and 86, differed in the production of 2-phenethylpropionate. This ester of phenethyl alcohol and propionic acid has shown antifungal activity and has been tested as a pesticide [134,135]. Meanwhile, M. pulcherrima 62 differed significantly from other yeasts tested for the production of 3-methylbutanoic acid and isobutyl isothiocyanate among VOCs (Figure 8).
Some of the VOCs are well-documented for their potent antifungal activity against plant pathogens, notably organic acids such as 3-methylbutanoic acid [118]. Additionally, the antifungal efficacy of isothiocyanates against both plant and food-borne pathogens has been extensively reported in the literature [136,137,138,139,140]. Isothiocyanates, derived from glucosinolate hydrolysis in cruciferous plants, are characterized by electrophilic carbon atoms that readily react with cellular thiols, disrupting protein structure and function [141]. These are organic compounds containing the isothiocyanate group RN=C=S. It is thought that this functional group has highly electrophilic carbon atoms, which make it easy to react with thiols in cells, such as cysteine in proteins and low molecular weight thiols (especially glutathione). This change results in the loss of protein structure and function. Isothiocyanate exhibits antifungal activity by targeting cell membrane integrity, cell cycle progression, and oxidative stress [140,142,143]. Isothiocyanates are reported not only to be antifungal but also to affect the growth and survival of some insect larvae [144]. However, several studies have shown that the larvae of some insects have the ability to detoxify isothiocyanates [145] and that no significant effects on honeybee development and mortality were observed in treatment with isothiocyanates against Nosema ceranae [146].
Pyrazines, including 2-methylpyrazine, produced by M. pulcherrima 86 and 62 (Table S5, Supplementary Materials), are widely studied due to their diverse biological applications. These aromatic hydrocarbons are generally recognized as safe (GRAS) and are commonly found in potatoes, coffee beans, cocoa beans, nuts, beef, and tobacco [147,148]. In addition, pyrazine derivatives continue to attract the attention of several researchers because of their diverse biological applications, such as being used as antifungal agents [149,150].
Finally, the detection of styrene among VOCs in the control sample (Aapis_Ctr) is likely attributable to contamination from plastic materials used during testing, as styrene is commonly emitted from plastics [151,152]. Additionally, certain molds can synthesize styrene from phenylalanine via ammonia-lyase activity followed by cinnamic acid decarboxylation [153,154].
4. Conclusions
In recent years, there has been a growing demand for safe and sustainable agricultural products, driving significant interest in biological control agents as viable alternatives to chemical pesticides. Biological control methods, particularly those involving biocontrol agents, offer a promising and environmentally friendly substitute for chemical fungicides, which are increasingly scrutinized due to concerns over food contamination and environmental pollution.
This study represents the first report on the antifungal activity of volatile organic compounds (VOCs) produced by M. pulcherrima against A. apis. The findings indicate that the antifungal properties of M. pulcherrima against A. apis may involve multiple mechanisms, including nutrient competition, the secretion of iron-chelating agents (pulcherriminic acid), and the biosynthesis of specific antifungal VOCs.
While this research provides a robust foundation for understanding the yeast’s biocontrol mechanisms, further investigation will be carried out to assess the individual and combined effects of the identified VOCs in controlled experimental settings. Such studies could elucidate potential synergistic interactions that enhance antifungal efficacy against A. apis. Furthermore, in the future, it is important to evaluate the effect of M. pulcherrima VOCs on the brood of healthy honeybees to demonstrate their safety and identify an application strategy without altering the environmental conditions of the hive and the productivity of honeybee colonies.
Ultimately, this approach may be useful for the development of innovative biocontrol strategies aimed at mitigating chalkbrood disease in honeybee colonies.
Supplementary Materials
The following supporting information can be downloaded at https://www.mdpi.com/article/10.3390/jof11050336/s1: Table S1. Fungal isolates list; Table S2. Composition of the culture media used for growth tests of Ascosphaera apis; Table S3. BC antifungal activity; Table S4. VOCs antifungal activity; Table S5. VOCs raw data.
Author Contributions
Conceptualization, M.I.; methodology, M.I. and R.C.; software, G.P. and G.A.; validation, F.C., S.G. and C.T.; formal analysis, C.M., G.A., L.M.D.D. and R.C.; investigation, M.I. and A.D.C.; data curation, G.P. and G.A.; writing—original draft preparation, M.I. and G.A.; writing—review and editing, M.I., S.G. and G.A.; visualization, S.G. and V.P.I.; supervision, M.I. and A.D.C. All authors have read and agreed to the published version of the manuscript.
Funding
This research received no external funding.
Institutional Review Board Statement
Not applicable.
Informed Consent Statement
Not applicable.
Data Availability Statement
The original contributions presented in this study are included in the article/Supplementary Materials. Further inquiries can be directed to the corresponding authors.
Conflicts of Interest
The authors declare no conflicts of interest.
References
- Potts, S.G.; Imperatriz-Fonseca, V.; Ngo, H.T.; Aizen, M.A.; Biesmeijer, J.C.; Breeze, T.D.; Dicks, L.V.; Garibaldi, L.A.; Hill, R.; Settele, J.; et al. Safeguarding Pollinators and Their Values to Human Well-Being. Nature 2016, 540, 220–229. [Google Scholar] [CrossRef] [PubMed]
- Klein, A.-M.; Vaissiere, B.E.; Cane, J.H.; Steffan-Dewenter, I.; Cunningham, S.A.; Kremen, C.; Tscharntke, T. Importance of Pollinators in Changing Landscapes for World Crops. Proc. R. Soc. B Biol. Sci. 2007, 274, 303–313. [Google Scholar] [CrossRef] [PubMed]
- Ollerton, J.; Winfree, R.; Tarrant, S. How Many Flowering Plants Are Pollinated by Animals? Oikos 2011, 120, 321–326. [Google Scholar] [CrossRef]
- Smith, M.R.; Singh, G.M.; Mozaffarian, D.; Myers, S.S. Effects of Decreases of Animal Pollinators on Human Nutrition and Global Health: A Modelling Analysis. Lancet 2015, 386, 1964–1972. [Google Scholar] [CrossRef] [PubMed]
- Lautenbach, S.; Seppelt, R.; Liebscher, J.; Dormann, C.F. Spatial and Temporal Trends of Global Pollination Benefit. PLoS ONE 2012, 7, e35954. [Google Scholar] [CrossRef]
- Home|Global Action on Pollination Services for Sustainable Agriculture|Food and Agriculture Organization of the United Nations. Available online: https://www.fao.org/pollination/en/ (accessed on 17 March 2025).
- Zattara, E.E.; Aizen, M.A. Worldwide Occurrence Records Suggest a Global Decline in Bee Species Richness. One Earth 2021, 4, 114–123. [Google Scholar] [CrossRef]
- Goulson, D.; Nicholls, E.; Botías, C.; Rotheray, E.L. Bee Declines Driven by Combined Stress from Parasites, Pesticides, and Lack of Flowers. Science 2015, 347, 1255957. [Google Scholar] [CrossRef]
- Siviter, H.; Bailes, E.J.; Martin, C.D.; Oliver, T.R.; Koricheva, J.; Leadbeater, E.; Brown, M.J.F. Agrochemicals Interact Synergistically to Increase Bee Mortality. Nature 2021, 596, 389–392. [Google Scholar] [CrossRef]
- Steinhauer, N.; Kulhanek, K.; Antúnez, K.; Human, H.; Chantawannakul, P.; Chauzat, M.-P.; vanEngelsdorp, D. Drivers of Colony Losses. Curr. Opin. Insect Sci. 2018, 26, 142–148. [Google Scholar] [CrossRef]
- Hallmann, C.A.; Sorg, M.; Jongejans, E.; Siepel, H.; Hofland, N.; Schwan, H.; Stenmans, W.; Müller, A.; Sumser, H.; Hörren, T.; et al. More than 75 Percent Decline over 27 Years in Total Flying Insect Biomass in Protected Areas. PLoS ONE 2017, 12, e0185809. [Google Scholar] [CrossRef]
- Raven, P.H.; Wagner, D.L. Agricultural Intensification and Climate Change Are Rapidly Decreasing Insect Biodiversity. Proc. Natl. Acad. Sci. USA 2021, 118, e2002548117. [Google Scholar] [CrossRef] [PubMed]
- Meeus, I.; Pisman, M.; Smagghe, G.; Piot, N. Interaction Effects of Different Drivers of Wild Bee Decline and Their Influence on Host-Pathogen Dynamics. Curr. Opin. Insect Sci. 2018, 26, 136–141. [Google Scholar] [CrossRef]
- Drossart, M.; Gérard, M. Beyond the Decline of Wild Bees: Optimizing Conservation Measures and Bringing Together the Actors. Insects 2020, 11, 649. [Google Scholar] [CrossRef]
- Smith, K.M.; Loh, E.H.; Rostal, M.K.; Zambrana-Torrelio, C.M.; Mendiola, L.; Daszak, P. Pathogens, Pests, and Economics: Drivers of Honey Bee Colony Declines and Losses. EcoHealth 2013, 10, 434–445. [Google Scholar] [CrossRef]
- Potts, S.G.; Biesmeijer, J.C.; Kremen, C.; Neumann, P.; Schweiger, O.; Kunin, W.E. Global Pollinator Declines: Trends, Impacts and Drivers. Trends Ecol. Evol. 2010, 25, 345–353. [Google Scholar] [CrossRef] [PubMed]
- Maxfield-Taylor, S.A.; Mujic, A.B.; Rao, S. First Detection of the Larval Chalkbrood Disease Pathogen Ascosphaera apis (Ascomycota: Eurotiomycetes: Ascosphaerales) in Adult Bumble Bees. PLoS ONE 2015, 10, e0124868. [Google Scholar] [CrossRef]
- Reynaldi, F.J.; Lucia, M.; Genchi Garcia, M.L. Ascosphaera apis, the Entomopathogenic Fungus Affecting Larvae of Native Bees (Xylocopa augusti): First Report in South America. Rev. Iberoam. Micol. 2015, 32, 261–264. [Google Scholar] [CrossRef]
- Deneke, Y. Review on Chalkbrood Disease of Honey Bee. Vet. Med. Open J. 2023, 8, 47–55. [Google Scholar] [CrossRef]
- Chen, D.; Guo, R.; Xiong, C.; Zheng, Y.; Hou, C.; Fu, Z. Morphological and Molecular Identification of Chalkbrood Disease Pathogen Ascosphaera apis in Apis Cerana Cerana. J. Apic. Res. 2018, 57, 516–521. [Google Scholar] [CrossRef]
- Tejerina, M.R.; Benitez-Ahrendts, M.R. Pathogenicity Bioassays of Ascosphaera apis Strains from Spanish Provinces in Bee Larvae from Northern Argentina. J. Apic. Res. 2023, 62, 488–495. [Google Scholar] [CrossRef]
- Karthik, V.; Srinivasan, M.R.; Saminathan, V.R.; Karthikeyan, S.; Balasubramani, V. Morphological and Molecular Identification and Mating Type Detection of Chalkbrood Fungal Pathogen Ascosphaera apis in Apis mellifera L. in Southern India. Indian J. Entomol. 2024, 1–7. [Google Scholar] [CrossRef]
- Sevim, A.; Akpınar, R.; Karaoğlu, Ş.A.; Bozdeveci, A.; Sevim, E. Prevalence and Phylogenetic Analysis of Ascosphaera apis (Maassen Ex Claussen) LS Olive & Spiltoir (1955) Isolates from Honeybee Colonies in Turkey. Biologia 2022, 77, 2689–2699. [Google Scholar] [CrossRef]
- Das, R.; Kumar, R.; Kunal, G.; Goldar, S.; Dutta, S.; Jha, S. Detection of Ascosphaera apis, Causing Chalkbrood Disease in the Colonies of European Honey Bee, Apis Mellifera in West Bengal, India. Sociobiology 2023, 70, e9192. [Google Scholar] [CrossRef]
- Pereira, K.D.S.; Meeus, I.; Smagghe, G. Honey Bee-Collected Pollen Is a Potential Source of Ascosphaera apis Infection in Managed Bumble Bees. Sci. Rep. 2019, 9, 4241. [Google Scholar] [CrossRef]
- Pavlović, R.; Brodschneider, R.; Goessler, W.; Stanisavljević, L.; Vujčić, Z.; Zarić, N.M. Micronutrient Deficiency May Be Associated with the Onset of Chalkbrood Disease in Honey Bees. Insects 2024, 15, 269. [Google Scholar] [CrossRef] [PubMed]
- Li, Z.; Su, S.; Hamilton, M.; Yan, L.; Chen, Y. The Ability to Cause Infection in a Pathogenic Fungus Uncovers a New Biological Feature of Honey Bee Viruses. J. Invertebr. Pathol. 2014, 120, 18–22. [Google Scholar] [CrossRef] [PubMed]
- Cheng, X.; Zhang, L.; Luo, J.; Yang, S.; Deng, Y.; Li, J.; Hou, C. Two Pathogenic Fungi Isolated from Chalkbrood Samples and Honey Bee Viruses They Carried. Front. Microbiol. 2022, 13, 843842. [Google Scholar] [CrossRef]
- Yoder, J.A.; Jajack, A.J.; Cornacchione, W.S.; Dunn, A.L.; Cunningham, E.G.; Matchett, C.L.; Rosselot, A.E. In Vitro Evaluation of Sugar Syrups, Antibiotics, and Miticides on Growth of Honey Bee Pathogen, Ascosphaera apis: Emphasis for Chalkbrood Prevention Is on Keeping Bees Healthy. Apidologie 2014, 45, 568–578. [Google Scholar] [CrossRef]
- Castagnino, G.L.B.; Mateos, A.; Meana, A.; Montejo, L.; Zamorano Iturralde, L.V.; Cutuli De Simón, M.T. Etiology, Symptoms and Prevention of Chalkbrood Disease: A Literature Review. Rev. Bras. Saúde E Produção Anim. 2020, 21, e210332020. [Google Scholar] [CrossRef]
- Kim, D.Y.; Maeng, S.; Cho, S.-J.; Park, H.J.; Kim, K.; Lee, J.K.; Srinivasan, S. The Ascosphaera apis Infection (Chalkbrood Disease) Alters the Gut Bacteriome Composition of the Honeybee. Pathogens 2023, 12, 734. [Google Scholar] [CrossRef]
- Khan, S.; Somerville, D.; Frese, M.; Nayudu, M. Environmental Gut Bacteria in European Honey Bees (Apis mellifera) from Australia and Their Relationship to the Chalkbrood Disease. PLoS ONE 2020, 15, e0238252. [Google Scholar] [CrossRef] [PubMed]
- Iorizzo, M.; Lombardi, S.J.; Ganassi, S.; Testa, B.; Ianiro, M.; Letizia, F.; Succi, M.; Tremonte, P.; Vergalito, F.; Cozzolino, A.; et al. Antagonistic Activity against Ascosphaera apis and Functional Properties of Lactobacillus Kunkeei Strains. Antibiotics 2020, 9, 262. [Google Scholar] [CrossRef] [PubMed]
- Iorizzo, M.; Testa, B.; Ganassi, S.; Lombardi, S.J.; Ianiro, M.; Letizia, F.; Succi, M.; Tremonte, P.; Vergalito, F.; Cozzolino, A.; et al. Probiotic Properties and Potentiality of Lactiplantibacillus Plantarum Strains for the Biological Control of Chalkbrood Disease. J. Fungi. 2021, 7, 379. [Google Scholar] [CrossRef]
- von Knoblauch, T.; Jensen, A.B.; Mülling, C.K.W.; Aupperle-Lellbach, H.; Genersch, E. Chalkbrood Disease Caused by Ascosphaera apis in Honey Bees (Apis mellifera)—Morphological and Histological Changes in Infected Larvae. Vet. Sci. 2024, 11, 415. [Google Scholar] [CrossRef] [PubMed]
- Boonmee, T.; Sinpoo, C.; Thayatham, K.; Suanpoot, P.; Disayathanoowat, T.; Pettis, J.S.; Chaimanee, V. Atmospheric Non-Thermal Plasma Inactivation of Ascosphaera apis, the Causative Agent of Chalkbrood Disease in Honeybee. Sci. Rep. 2024, 14, 1831. [Google Scholar] [CrossRef]
- Ansari, M.J.; Al-Ghamdi, A.; Usmani, S.; Khan, K.A.; Alqarni, A.S.; Kaur, M.; Al-Waili, N. In Vitro Evaluation of the Effects of Some Plant Essential Oils on Ascosphaera apis, the Causative Agent of Chalkbrood Disease. Saudi J. Biol. Sci. 2017, 24, 1001–1006. [Google Scholar] [CrossRef]
- Usta, M. Biological Control of Honey Bee Diseases and Pests. In Melittology—New Advances; IntechOpen: London, UK, 2023; ISBN 978-1-83769-370-2. [Google Scholar]
- Krutmuang, P.; Rajula, J.; Pittarate, S.; Chatima, C.; Thungrabeab, M.; Mekchay, S.; Senthil-Nathan, S. The Inhibitory Action of Plant Extracts on the Mycelial Growth of Ascosphaera apis, the Causative Agent of Chalkbrood Disease in Honey Bee. Toxicol. Rep. 2022, 9, 713–719. [Google Scholar] [CrossRef]
- Pusceddu, M.; Floris, I.; Mangia, N.P.; Angioni, A.; Satta, A. In Vitro Activity of Several Essential Oils Extracted from Aromatic Plants against Ascosphaera apis. Vet. Sci. 2021, 8, 80. [Google Scholar] [CrossRef]
- Khan, S.U.; Anjum, S.I.; Ansari, M.J.; Khan, M.H.U.; Kamal, S.; Rahman, K.; Shoaib, M.; Man, S.; Khan, A.J.; Khan, S.U.; et al. Antimicrobial Potentials of Medicinal Plant’s Extract and Their Derived Silver Nanoparticles: A Focus on Honey Bee Pathogen. Saudi J. Biol. Sci. 2019, 26, 1815–1834. [Google Scholar] [CrossRef]
- Abdi, K.; Ben Said, M.; Crotti, E.; Masmoudi, A.S.; Cherif, A. The Promise of Probiotics in Honeybee Health and Disease Management. Arch. Microbiol. 2023, 205, 73. [Google Scholar] [CrossRef]
- Iorizzo, M.; Letizia, F.; Ganassi, S.; Testa, B.; Petrarca, S.; Albanese, G.; Di Criscio, D.; De Cristofaro, A. Functional Properties and Antimicrobial Activity from Lactic Acid Bacteria as Resources to Improve the Health and Welfare of Honey Bees. Insects 2022, 13, 308. [Google Scholar] [CrossRef] [PubMed]
- Rodríguez, M.A.; Fernández, L.A.; Díaz, M.L.; Pérez, M.; Corona, M.; Reynaldi, F.J. Microbiological and Chemical Characterization of Water Kefir: An Innovative Source of Potential Probiotics for Bee Nutrition. Rev. Argent. Microbiol. 2023, 55, 176–180. [Google Scholar] [CrossRef]
- Tejerina, M.R.; Benítez-Ahrendts, M.R.; Audisio, M.C. Lactobacillus salivarius A3iob Reduces the Incidence of Varroa destructor and Nosema Spp. in Commercial Apiaries Located in the Northwest of Argentina. Probiotics Antimicrob. Proteins 2020, 12, 1360–1369. [Google Scholar] [CrossRef] [PubMed]
- Motta, E.V.; Moran, N.A. The Honeybee Microbiota and Its Impact on Health and Disease. Nat. Rev. Microbiol. 2024, 22, 122–137. [Google Scholar] [CrossRef]
- Kwong, W.K.; Moran, N.A. Gut Microbial Communities of Social Bees. Nat. Rev. Microbiol. 2016, 14, 374–384. [Google Scholar] [CrossRef] [PubMed]
- Zheng, H.; Nishida, A.; Kwong, W.K.; Koch, H.; Engel, P.; Steele, M.I.; Moran, N.A. Metabolism of Toxic Sugars by Strains of the Bee Gut Symbiont Gilliamella Apicola. mBio 2016, 7, e01326-16. [Google Scholar] [CrossRef]
- Iorizzo, M.; Pannella, G.; Lombardi, S.J.; Ganassi, S.; Testa, B.; Succi, M.; Sorrentino, E.; Petrarca, S.; De Cristofaro, A.; Coppola, R.; et al. Inter- and Intra-Species Diversity of Lactic Acid Bacteria in Apis mellifera ligustica Colonies. Microorganisms 2020, 8, 1578. [Google Scholar] [CrossRef]
- Stefanini, I. Yeast-Insect Associations: It Takes Guts. Yeast Chichester Engl. 2018, 35, 315–330. [Google Scholar] [CrossRef]
- Malassigné, S.; Minard, G.; Vallon, L.; Martin, E.; Valiente Moro, C.; Luis, P. Diversity and Functions of Yeast Communities Associated with Insects. Microorganisms 2021, 9, 1552. [Google Scholar] [CrossRef]
- Vega, F.E.; Blackwell, M. Insect-Fungal Associations: Ecology and Evolution; Oxford University Press: Oxford, UK, 2005; ISBN 978-0-19-803727-9. [Google Scholar]
- Callegari, M.; Crotti, E.; Fusi, M.; Marasco, R.; Gonella, E.; De Noni, I.; Romano, D.; Borin, S.; Tsiamis, G.; Cherif, A.; et al. Compartmentalization of Bacterial and Fungal Microbiomes in the Gut of Adult Honeybees. Npj Biofilms Microbiomes 2021, 7, 42. [Google Scholar] [CrossRef]
- Rutkowski, D.; Weston, M.; Vannette, R.L. Bees Just Wanna Have Fungi: A Review of Bee Associations with Nonpathogenic Fungi. FEMS Microbiol. Ecol. 2023, 99, fiad077. [Google Scholar] [CrossRef] [PubMed]
- Agarbati, A.; Gattucci, S.; Canonico, L.; Ciani, M.; Comitini, F. Yeast Communities Related to Honeybees: Occurrence and Distribution in Flowers, Gut Mycobiota, and Bee Products. Appl. Microbiol. Biotechnol. 2024, 108, 175. [Google Scholar] [CrossRef]
- Agarbati, A.; Moretti, L.; Canonico, L.; Ciani, M.; Comitini, F. Agro-Ecosystem of Honeybees as Source for Native Probiotic Yeasts. World J. Microbiol. Biotechnol. 2024, 40, 147. [Google Scholar] [CrossRef]
- Detry, R.; Simon-Delso, N.; Bruneau, E.; Daniel, H.-M. Specialisation of Yeast Genera in Different Phases of Bee Bread Maturation. Microorganisms 2020, 8, 1789. [Google Scholar] [CrossRef] [PubMed]
- Lachance, M.-A.; Starmer, W.T.; Rosa, C.A.; Bowles, J.M.; Barker, J.S.F.; Janzen, D.H. Biogeography of the Yeasts of Ephemeral Flowers and Their Insects. FEMS Yeast Res. 2001, 1, 1–8. [Google Scholar] [CrossRef]
- Palmieri, D.; Ianiri, G.; Del Grosso, C.; Barone, G.; De Curtis, F.; Castoria, R.; Lima, G. Advances and Perspectives in the Use of Biocontrol Agents against Fungal Plant Diseases. Horticulturae 2022, 8, 577. [Google Scholar] [CrossRef]
- Al-Nijir, M.; Henk, D.A.; Bedford, M.R.; Chuck, C.J. Assessing Metschnikowia Pulcherrima as a Potential Probiotic Yeast for Animal Feed. Sustain. Microbiol. 2024, 1, qvae008. [Google Scholar] [CrossRef]
- Hicks, R.H.; Moreno-Beltrán, M.; Gore-Lloyd, D.; Chuck, C.J.; Henk, D.A. The Oleaginous Yeast Metschnikowia Pulcherrima Displays Killer Activity against Avian-Derived Pathogenic Bacteria. Biology 2021, 10, 1227. [Google Scholar] [CrossRef]
- Cristina Vergara Alvarez, S.; José Leiva Alaniz, M.; Victoria Mestre Furlani, M.; Vazquez, F.; Mancha Agresti, P.; Cristina Nally, M.; Paola Maturano, Y. Bioprospecting of the Probiotic Potential of Yeasts Isolated from a Wine Environment. Fungal Genet. Biol. 2023, 164, 103767. [Google Scholar] [CrossRef]
- Staniszewski, A.; Kordowska-Wiater, M. Probiotic Yeasts and How to Find Them—Polish Wines of Spontaneous Fermentation as Source for Potentially Probiotic Yeasts. Foods 2023, 12, 3392. [Google Scholar] [CrossRef]
- Diguță, C.F.; Mihai, C.; Toma, R.C.; Cîmpeanu, C.; Matei, F. In Vitro Assessment of Yeasts Strains with Probiotic Attributes for Aquaculture Use. Foods 2023, 12, 124. [Google Scholar] [CrossRef]
- Yildiran, H.; Başyiğit Kiliç, G.; Karahan Çakmakçi, A.G. Characterization and Comparison of Yeasts from Different Sources for Some Probiotic Properties and Exopolysaccharide Production. Food Sci. Technol. 2019, 39, 646–653. [Google Scholar] [CrossRef]
- MendonçA-Hagler, L.C.; Hagler, A.N.; Kurtzman, C.P. Phylogeny of Metschnikowia Species Estimated from Partial rRNA Sequences. Int. J. Syst. Evol. Microbiol. 1993, 43, 368–373. [Google Scholar] [CrossRef] [PubMed]
- Sipiczki, M. Metschnikowia Pulcherrima and Related Pulcherrimin-Producing Yeasts: Fuzzy Species Boundaries and Complex Antimicrobial Antagonism. Microorganisms 2020, 8, 1029. [Google Scholar] [CrossRef]
- Kregiel, D.; Nowacka, M.; Rygala, A.; Vadkertiová, R. Biological Activity of Pulcherrimin from the Meschnikowia Pulcherrima Clade. Molecules 2022, 27, 1855. [Google Scholar] [CrossRef]
- Commenges, A.; Lessard, M.-H.; Coucheney, F.; Labrie, S.; Drider, D. The Biopreservative Properties of Metschnikowia pulcherrima LMA 2038 and Trichosporon asahii LMA 810 in a Model Fresh Cheese, Are Presented. Food Biosci. 2024, 58, 103458. [Google Scholar] [CrossRef]
- Oro, L.; Feliziani, E.; Ciani, M.; Romanazzi, G.; Comitini, F. Biocontrol of Postharvest Brown Rot of Sweet Cherries by Saccharomyces cerevisiae Disva 599, Metschnikowia pulcherrima Disva 267 and Wickerhamomyces anomalus Disva 2 Strains. Postharvest Biol. Technol. 2014, 96, 64–68. [Google Scholar] [CrossRef]
- Oro, L.; Feliziani, E.; Ciani, M.; Romanazzi, G.; Comitini, F. Volatile Organic Compounds from Wickerhamomyces anomalus, Metschnikowia pulcherrima and Saccharomyces cerevisiae Inhibit Growth of Decay Causing Fungi and Control Postharvest Diseases of Strawberries. Int. J. Food Microbiol. 2018, 265, 18–22. [Google Scholar] [CrossRef]
- Settier-Ramírez, L.; López-Carballo, G.; Hernández-Muñoz, P.; Fontana, A.; Strub, C.; Schorr-Galindo, S. New Isolated Metschnikowia Pulcherrima Strains from Apples for Postharvest Biocontrol of Penicillium Expansum and Patulin Accumulation. Toxins 2021, 13, 397. [Google Scholar] [CrossRef]
- Lombardo, M.F.; Panebianco, S.; Restuccia, C.; Cirvilleri, G. Biocontrol Efficacy of Metschnikowia spp. Yeasts in Organic Vineyards against Major Airborne Diseases of Table Grapes in the Field and in Postharvest. Foods 2023, 12, 3508. [Google Scholar] [CrossRef]
- Puyo, M.; Simonin, S.; Bach, B.; Klein, G.; Alexandre, H.; Tourdot-Maréchal, R. Bio-Protection in Oenology by Metschnikowia Pulcherrima: From Field Results to Scientific Inquiry. Front. Microbiol. 2023, 14, 1252973. [Google Scholar] [CrossRef] [PubMed]
- Bühlmann, A.; Kammerecker, S.; Müller, L.; Hilber-Bodmer, M.; Perren, S.; Freimoser, F.M. Stability of Dry and Liquid Metschnikowia Pulcherrima Formulations for Biocontrol Applications against Apple Postharvest Diseases. Horticulturae 2021, 7, 459. [Google Scholar] [CrossRef]
- Steglińska, A.; Kołtuniak, A.; Berłowska, J.; Czyżowska, A.; Szulc, J.; Cieciura-Włoch, W.; Okrasa, M.; Kręgiel, D.; Gutarowska, B. Metschnikowia Pulcherrima as a Biocontrol Agent against Potato (Solanum tuberosum) Pathogens. Agronomy 2022, 12, 2546. [Google Scholar] [CrossRef]
- Fernandez-San Millan, A.; Fernandez-Irigoyen, J.; Santamaria, E.; Larraya, L.; Farran, I.; Veramendi, J. Metschnikowia pulcherrima as an Efficient Biocontrol Agent of Botrytis cinerea Infection in Apples: Unraveling Protection Mechanisms through Yeast Proteomics. Biol. Control 2023, 183, 105266. [Google Scholar] [CrossRef]
- Oztekin, S.; Karbancioglu-Guler, F. Bioprospection of Metschnikowia sp. Isolates as Biocontrol Agents against Postharvest Fungal Decays on Lemons with Their Potential Modes of Action. Postharvest Biol. Technol. 2021, 181, 111634. [Google Scholar] [CrossRef]
- Türkel, S.; Korukluoğlu, M.; Yavuz, M. Biocontrol Activity of the Local Strain of Metschnikowia Pulcherrima on Different Postharvest Pathogens. Biotechnol. Res. Int. 2014, 2014, 397167. [Google Scholar] [CrossRef] [PubMed]
- Canonico, L.; Agarbati, A.; Galli, E.; Comitini, F.; Ciani, M. Metschnikowia pulcherrima as Biocontrol Agent and Wine Aroma Enhancer in Combination with a Native Saccharomyces cerevisiae. LWT 2023, 181, 114758. [Google Scholar] [CrossRef]
- De Curtis, F.; de Felice, D.V.; Ianiri, G.; De Cicco, V.; Castoria, R. Environmental Factors Affect the Activity of Biocontrol Agents against Ochratoxigenic Aspergillus Carbonarius on Wine Grape. Int. J. Food Microbiol. 2012, 159, 17–24. [Google Scholar] [CrossRef]
- Gross, S.; Kunz, L.; Müller, D.C.; Santos Kron, A.; Freimoser, F.M. Characterization of Antagonistic Yeasts for Biocontrol Applications on Apples or in Soil by Quantitative Analyses of Synthetic Yeast Communities. Yeast 2018, 35, 559–566. [Google Scholar] [CrossRef]
- Li, Z.; Liu, Q.; Wu, C.; Yuan, Y.; Ni, X.; Wu, T.; Chang, R.; Wang, Y. Volatile Organic Compounds Produced by Metschnikowia pulcherrima Yeast T-2 Inhibited the Growth of Botrytis cinerea in Postharvest Blueberry Fruits. Hortic. Plant J. 2024, in press. [Google Scholar] [CrossRef]
- Karaulli, J.; Xhaferaj, N.; Coppola, F.; Testa, B.; Letizia, F.; Kyçyk, O.; Kongoli, R.; Ruci, M.; Lamçe, F.; Sulaj, K.; et al. Bioprospecting of Metschnikowia Pulcherrima Strains, Isolated from a Vineyard Ecosystem, as Novel Starter Cultures for Craft Beer Production. Fermentation 2024, 10, 513. [Google Scholar] [CrossRef]
- Testa, B.; Coppola, F.; Iorizzo, M.; Di Renzo, M.; Coppola, R.; Succi, M. Preliminary Characterisation of Metschnikowia Pulcherrima to Be Used as a Starter Culture in Red Winemaking. Beverages 2024, 10, 88. [Google Scholar] [CrossRef]
- Iorizzo, M.; Bagnoli, D.; Vergalito, F.; Testa, B.; Tremonte, P.; Succi, M.; Pannella, G.; Letizia, F.; Albanese, G.; Lombardi, S.J.; et al. Diversity of Fungal Communities on Cabernet and Aglianico Grapes from Vineyards Located in Southern Italy. Front. Microbiol. 2024, 15, 1399968. [Google Scholar] [CrossRef] [PubMed]
- Jensen, A.B.; Aronstein, K.; Flores, J.M.; Vojvodic, S.; Palacio, M.A.; Spivak, M. Standard Methods for Fungal Brood Disease Research. J. Apic. Res. 2013, 52, 1–20. [Google Scholar] [CrossRef]
- Mbareche, H.; Veillette, M.; Bilodeau, G.; Duchaine, C. Comparison of the Performance of ITS1 and ITS2 as Barcodes in Amplicon-Based Sequencing of Bioaerosols. PeerJ 2020, 8, e8523. [Google Scholar] [CrossRef]
- Nucleotide BLAST. Available online: https://blast.ncbi.nlm.nih.gov/Blast.cgi?PROGRAM=blastn&PAGE_TYPE=BlastSearch&LINK_LOC=blasthome (accessed on 19 March 2024).
- NCBI Resource Coordinators. Database Resources of the National Center for Biotechnology Information. Nucleic Acids Res. 2018, 46, D8–D13. [Google Scholar] [CrossRef]
- MM18: DNA Target Sequencing & Bacteria & Fungi ID—CLSI. Available online: https://clsi.org/standards/products/molecular-diagnostics/documents/mm18/ (accessed on 3 March 2025).
- Kimura, M. A Simple Method for Estimating Evolutionary Rates of Base Substitutions through Comparative Studies of Nucleotide Sequences. J. Mol. Evol. 1980, 16, 111–120. [Google Scholar] [CrossRef]
- Tamura, K.; Stecher, G.; Kumar, S. MEGA11: Molecular Evolutionary Genetics Analysis Version 11. Mol. Biol. Evol. 2021, 38, 3022–3027. [Google Scholar] [CrossRef]
- Parafati, L.; Vitale, A.; Restuccia, C.; Cirvilleri, G. Biocontrol Ability and Action Mechanism of Food-Isolated Yeast Strains against Botrytis cinerea Causing Post-Harvest Bunch Rot of Table Grape. Food Microbiol. 2015, 47, 85–92. [Google Scholar] [CrossRef]
- Ruiz-Moyano, S.; Hernández, A.; Galvan, A.I.; Córdoba, M.G.; Casquete, R.; Serradilla, M.J.; Martín, A. Selection and Application of Antifungal VOCs-Producing Yeasts as Biocontrol Agents of Grey Mould in Fruits. Food Microbiol. 2020, 92, 103556. [Google Scholar] [CrossRef]
- Serradilla, M.J.; Martín, A.; Hernandez, A.; López-Corrales, M.; Lozano, M.; Córdoba, M. de G. Effect of the Commercial Ripening Stage and Postharvest Storage on Microbial and Aroma Changes of ‘Ambrunés’ Sweet Cherries. J. Agric. Food Chem. 2010, 58, 9157–9163. [Google Scholar] [CrossRef] [PubMed]
- Rieppel, O. Species Monophyly. J. Zool. Syst. Evol. Res. 2010, 48, 1–8. [Google Scholar] [CrossRef]
- Mráz, P.; Hýbl, M.; Kopecký, M.; Bohatá, A.; Konopická, J.; Hoštičková, I.; Konvalina, P.; Šipoš, J.; Rost, M.; Čurn, V. The Effect of Artificial Media and Temperature on the Growth and Development of the Honey Bee Brood Pathogen Ascosphaera apis. Biology 2021, 10, 431. [Google Scholar] [CrossRef] [PubMed]
- Karthik, V.; Srinivasan, M.R.; Saminathan, V.R.; Karthikeyan, S.; Balasubramani, V. Effect of Media on the Mycelial Growth of Honey Bee Fungal Pathogen Ascosphaera apis Mating Types. Indian J. Entomol. 2024, 1–4. [Google Scholar] [CrossRef]
- Huber, J. Untersuchungen zur Physiologie insektentötender Pilze. Arch. Für Mikrobiol. 1958, 29, 257–276. [Google Scholar] [CrossRef]
- Anderson, D.L.; Gibson, N.L. New Species and Isolates of Spore-Cyst Fungi (Plectomycetes: Ascosphaerales) from Australia. Aust. Syst. Bot. 1998, 11, 53–72. [Google Scholar] [CrossRef]
- Stabentheiner, A.; Kovac, H.; Mandl, M.; Käfer, H. Coping with the Cold and Fighting the Heat: Thermal Homeostasis of a Superorganism, the Honeybee Colony. J. Comp. Physiol. A 2021, 207, 337–351. [Google Scholar] [CrossRef]
- Flores, J.M.; Ruiz, J.A.; Ruz, J.M.; Puerta, F.; Bustos, M.; Padilla, F.; Campano, F. Effect of Temperature and Humidity of Sealed Brood on Chalkbrood Development under Controlled Conditions. Apidologie 1996, 27, 185–192. [Google Scholar] [CrossRef]
- Medrzycki, P.; Sgolastra, F.; Bortolotti, L.; Bogo, G.; Tosi, S.; Padovani, E.; Porrini, C.; Sabatini, A.G. Influence of Brood Rearing Temperature on Honey Bee Development and Susceptibility to Poisoning by Pesticides. J. Apic. Res. 2010, 49, 52–59. [Google Scholar] [CrossRef]
- Wang, Q.; Xu, X.; Zhu, X.; Chen, L.; Zhou, S.; Huang, Z.Y.; Zhou, B. Low-Temperature Stress during Capped Brood Stage Increases Pupal Mortality, Misorientation and Adult Mortality in Honey Bees. PLoS ONE 2016, 11, e0154547. [Google Scholar] [CrossRef]
- Pawlikowska, E.; Kolesińska, B.; Nowacka, M.; Kregiel, D. A New Approach to Producing High Yields of Pulcherrimin from Metschnikowia Yeasts. Fermentation 2020, 6, 114. [Google Scholar] [CrossRef]
- Monnet, C.; Back, A.; Irlinger, F. Growth of Aerobic Ripening Bacteria at the Cheese Surface Is Limited by the Availability of Iron. Appl. Environ. Microbiol. 2012, 78, 3185–3192. [Google Scholar] [CrossRef] [PubMed]
- Pawlikowska, E. Enzymatic Profiles and Antimicrobial Activity of the Yeast Metschnikowia Pulcherrima. Acta Innov. 2017, 17–24. [Google Scholar]
- Yang, H.; Wang, L.; Li, S.; Gao, X.; Wu, N.; Zhao, Y.; Sun, W. Control of Postharvest Grey Spot Rot of Loquat Fruit with Metschnikowia pulcherrima E1 and Potential Mechanisms of Action. Biol. Control 2021, 152, 104406. [Google Scholar] [CrossRef]
- Ghorbanpour, M.; Omidvari, M.; Abbaszadeh-Dahaji, P.; Omidvar, R.; Kariman, K. Mechanisms Underlying the Protective Effects of Beneficial Fungi against Plant Diseases. Biol. Control 2018, 117, 147–157. [Google Scholar] [CrossRef]
- Colautti, A.; Camprini, L.; Ginaldi, F.; Comi, G.; Reale, A.; Coppola, F.; Iacumin, L. Safety Traits, Genetic and Technological Characterization of Lacticaseibacillus Rhamnosus Strains. LWT 2024, 207, 116578. [Google Scholar] [CrossRef]
- Coppola, F.; Abdalrazeq, M.; Fratianni, F.; Ombra, M.N.; Testa, B.; Zengin, G.; Ayala Zavala, J.F.; Nazzaro, F. Rosaceae Honey: Antimicrobial Activity and Prebiotic Properties. Antibiotics 2025, 14, 298. [Google Scholar] [CrossRef]
- Nazzaro, F.; Ombra, M.N.; Coppola, F.; De Giulio, B.; d’Acierno, A.; Coppola, R.; Fratianni, F. Antibacterial Activity and Prebiotic Properties of Six Types of Lamiaceae Honey. Antibiotics 2024, 13, 868. [Google Scholar] [CrossRef]
- Parafati, L.; Cirvilleri, G.; Restuccia, C.; Wisniewski, M. Potential Role of Exoglucanase Genes (WaEXG1 and WaEXG2) in the Biocontrol Activity of Wickerhamomyces anomalus. Microb. Ecol. 2017, 73, 876–884. [Google Scholar] [CrossRef]
- Millan, A.F.-S.; Gamir, J.; Farran, I.; Larraya, L.; Veramendi, J. Identification of New Antifungal Metabolites Produced by the Yeast Metschnikowia pulcherrima Involved in the Biocontrol of Postharvest Plant Pathogenic Fungi. Postharvest Biol. Technol. 2022, 192, 111995. [Google Scholar] [CrossRef]
- Lemos Junior, W.J.F.; Binati, R.L.; Felis, G.E.; Slaghenaufi, D.; Ugliano, M.; Torriani, S. Volatile Organic Compounds from Starmerella Bacillaris to Control Gray Mold on Apples and Modulate Cider Aroma Profile. Food Microbiol. 2020, 89, 103446. [Google Scholar] [CrossRef]
- Mari, M.; Bautista-Baños, S.; Sivakumar, D. Decay Control in the Postharvest System: Role of Microbial and Plant Volatile Organic Compounds. Postharvest Biol. Technol. 2016, 122, 70–81. [Google Scholar] [CrossRef]
- Zhao, X.; Zhou, J.; Tian, R.; Liu, Y. Microbial Volatile Organic Compounds: Antifungal Mechanisms, Applications, and Challenges. Front. Microbiol. 2022, 13, 922450. [Google Scholar] [CrossRef]
- Korpi, A.; Järnberg, J.; Pasanen, A.-L. Microbial Volatile Organic Compounds. Crit. Rev. Toxicol. 2009, 39, 139–193. [Google Scholar] [CrossRef] [PubMed]
- Chandrasekaran, M.; Paramasivan, M.; Sahayarayan, J.J. Microbial Volatile Organic Compounds: An Alternative for Chemical Fertilizers in Sustainable Agriculture Development. Microorganisms 2023, 11, 42. [Google Scholar] [CrossRef] [PubMed]
- Schulz-Bohm, K.; Martín-Sánchez, L.; Garbeva, P. Microbial Volatiles: Small Molecules with an Important Role in Intra- and Inter-Kingdom Interactions. Front. Microbiol. 2017, 8, 2484. [Google Scholar] [CrossRef]
- Veselova, M.A.; Plyuta, V.A.; Khmel, I.A. Volatile Compounds of Bacterial Origin: Structure, Biosynthesis, and Biological Activity. Microbiology 2019, 88, 261–274. [Google Scholar] [CrossRef]
- Contarino, R.; Brighina, S.; Fallico, B.; Cirvilleri, G.; Parafati, L.; Restuccia, C. Volatile Organic Compounds (VOCs) Produced by Biocontrol Yeasts. Food Microbiol. 2019, 82, 70–74. [Google Scholar] [CrossRef]
- Parafati, L.; Vitale, A.; Restuccia, C.; Cirvilleri, G. Performance Evaluation of Volatile Organic Compounds by Antagonistic Yeasts Immobilized on Hydrogel Spheres against Gray, Green and Blue Postharvest Decays. Food Microbiol. 2017, 63, 191–198. [Google Scholar] [CrossRef]
- Toral, L.; Rodríguez, M.; Martínez-Checa, F.; Montaño, A.; Cortés-Delgado, A.; Smolinska, A.; Llamas, I.; Sampedro, I. Corrigendum: Identification of Volatile Organic Compounds in Extremophilic Bacteria and Their Effective Use in Biocontrol of Postharvest Fungal Phytopathogens. Front. Microbiol. 2023, 14, 1267324. [Google Scholar] [CrossRef]
- Chaves-López, C.; Serio, A.; Gianotti, A.; Sacchetti, G.; Ndagijimana, M.; Ciccarone, C.; Stellarini, A.; Corsetti, A.; Paparella, A. Diversity of Food-Borne Bacillus Volatile Compounds and Influence on Fungal Growth. J. Appl. Microbiol. 2015, 119, 487–499. [Google Scholar] [CrossRef] [PubMed]
- Di Francesco, A.; Moret, E.; Cignola, R.; Garagozzo, L.; Torelli, E.; Di Foggia, M. Yeasts Volatile Organic Compounds (VOCs) as Potential Growth Enhancers and Molds Biocontrol Agents of Mushrooms Mycelia. Fungal Biol. 2024, 128, 1859–1867. [Google Scholar] [CrossRef]
- Yalage Don, S.M.; Schmidtke, L.M.; Gambetta, J.M.; Steel, C.C. Volatile Organic Compounds Produced by Aureobasidium pullulans Induce Electrolyte Loss and Oxidative Stress in Botrytis cinerea and Alternaria aternata. Res. Microbiol. 2021, 172, 103788. [Google Scholar] [CrossRef] [PubMed]
- Liu, Z.; Tian, J.; Yan, H.; Li, D.; Wang, X.; Liang, W.; Wang, G. Ethyl Acetate Produced by Hanseniaspora Uvarum Is a Potential Biocontrol Agent Against Tomato Fruit Rot Caused by Phytophthora Nicotianae. Front. Microbiol. 2022, 13, 978920. [Google Scholar] [CrossRef] [PubMed]
- Yalage Don, S.M.; Schmidtke, L.M.; Gambetta, J.M.; Steel, C.C. Aureobasidium pullulans Volatilome Identified by a Novel, Quantitative Approach Employing SPME-GC-MS, Suppressed Botrytis cinerea and Alternaria aternata In Vitro. Sci. Rep. 2020, 10, 4498. [Google Scholar] [CrossRef]
- Di Francesco, A.; Ugolini, L.; Lazzeri, L.; Mari, M. Production of Volatile Organic Compounds by Aureobasidium pullulans as a Potential Mechanism of Action against Postharvest Fruit Pathogens. Biol. Control 2015, 81, 8–14. [Google Scholar] [CrossRef]
- Gao, Y.; Ren, H.; He, S.; Duan, S.; Xing, S.; Li, X.; Huang, Q. Antifungal Activity of the Volatile Organic Compounds Produced by Ceratocystis Fimbriata Strains WSJK-1 and Mby. Front. Microbiol. 2022, 13, 1034939. [Google Scholar] [CrossRef]
- Zou, X.; Wei, Y.; Jiang, S.; Xu, F.; Wang, H.; Zhan, P.; Shao, X. ROS Stress and Cell Membrane Disruption Are the Main Antifungal Mechanisms of 2-Phenylethanol against Botrytis cinerea. J. Agric. Food Chem. 2022, 70, 14468–14479. [Google Scholar] [CrossRef]
- Dev, U.; Devakumar, C.; Mohan, J.; Agarwal, P.C. Antifungal Activity of Aroma Chemicals Against Seed-Borne Fungi. J. Essent. Oil Res. 2004, 16, 496–499. [Google Scholar] [CrossRef]
- Isman, M.B. Plant Essential Oils for Pest and Disease Management. Crop Prot. 2000, 19, 603–608. [Google Scholar] [CrossRef]
- Dufour, V.; Stahl, M.; Baysse, C. The Antibacterial Properties of Isothiocyanates. Microbiol. Read. Engl. 2015, 161, 229–243. [Google Scholar] [CrossRef] [PubMed]
- Romeo, L.; Iori, R.; Rollin, P.; Bramanti, P.; Mazzon, E. Isothiocyanates: An Overview of Their Antimicrobial Activity against Human Infections. Molecules 2018, 23, 624. [Google Scholar] [CrossRef]
- Zhang, M.; Li, Y.; Bi, Y.; Wang, T.; Dong, Y.; Yang, Q.; Zhang, T. 2-Phenylethyl Isothiocyanate Exerts Antifungal Activity against Alternaria aternata by Affecting Membrane Integrity and Mycotoxin Production. Toxins 2020, 12, 124. [Google Scholar] [CrossRef]
- Saladino, F.; Bordin, K.; Luciano, F.B.; Franzón, M.F.; Mañes, J.; Meca, G. Antimicrobial Activity of the Glucosinolates. In Glucosinolates; Mérillon, J.-M., Ramawat, K.G., Eds.; Springer International Publishing: Cham, Switerland, 2017; pp. 249–274. ISBN 978-3-319-25462-3. [Google Scholar]
- Yu, H.; Jia, W.; Zhao, M.; Li, L.; Liu, J.; Chen, J.; Pan, H.; Zhang, X. Antifungal Mechanism of Isothiocyanates Against. Pest Manag. Sci. 2022, 78, 5133–5141. [Google Scholar] [CrossRef] [PubMed]
- Olayanju, J.B.; Bozic, D.; Naidoo, U.; Sadik, O.A. A Comparative Review of Key Isothiocyanates and Their Health Benefits. Nutrients 2024, 16, 757. [Google Scholar] [CrossRef] [PubMed]
- Wang, T.; Li, Y.; Bi, Y.; Zhang, M.; Zhang, T.; Zheng, X.; Dong, Y.; Huang, Y. Benzyl Isothiocyanate Fumigation Inhibits Growth, Membrane Integrity and Mycotoxin Production in Alternaria aternata. RSC Adv. 2020, 10, 1829–1837. [Google Scholar] [CrossRef]
- Patil, S.B.; Basrani, S.T.; Chougule, S.A.; Gavandi, T.C.; Karuppayil, S.M.; Jadhav, A.K. Butyl Isothiocyanate Exhibits Antifungal and Anti-Biofilm Activity against Candida Albicans by Targeting Cell Membrane Integrity, Cell Cycle Progression and Oxidative Stress. Arch. Microbiol. 2024, 206, 251. [Google Scholar] [CrossRef]
- Jeschke, V.; Kearney, E.E.; Schramm, K.; Kunert, G.; Shekhov, A.; Gershenzon, J.; Vassão, D.G. How Glucosinolates Affect Generalist Lepidopteran Larvae: Growth, Development and Glucosinolate Metabolism. Front. Plant Sci. 2017, 8, 1995. [Google Scholar] [CrossRef]
- Sontowski, R.; Guyomar, C.; Poeschl, Y.; Weinhold, A.; van Dam, N.M.; Vassão, D.G. Mechanisms of Isothiocyanate Detoxification in Larvae of Two Belowground Herbivores, Delia Radicum and D. Floralis (Diptera: Anthomyiidae). Front. Physiol. 2022, 13, 874527. [Google Scholar] [CrossRef]
- Ugolini, L.; Cilia, G.; Pagnotta, E.; Malaguti, L.; Capano, V.; Guerra, I.; Zavatta, L.; Albertazzi, S.; Matteo, R.; Lazzeri, L.; et al. Glucosinolate Bioactivation by Apis Mellifera Workers and Its Impact on Nosema Ceranae Infection at the Colony Level. Biomolecules 2021, 11, 1657. [Google Scholar] [CrossRef]
- Adams, T.B.; Doull, J.; Feron, V.J.; Goodman, J.I.; Marnett, L.J.; Munro, I.C.; Newberne, P.M.; Portoghese, P.S.; Smith, R.L.; Waddell, W.J.; et al. The FEMA GRAS Assessment of Pyrazine Derivatives Used as Flavor Ingredients. Flavor and Extract Manufacturers Association. Food Chem. Toxicol. Int. J. Publ. Br. Ind. Biol. Res. Assoc. 2002, 40, 429–451. [Google Scholar] [CrossRef]
- Dolezal, M.; Zitko, J. Pyrazine Derivatives: A Patent Review (June 2012—Present). Expert Opin. Ther. Pat. 2015, 25, 33–47. [Google Scholar] [CrossRef] [PubMed]
- Kucerova-Chlupacova, M.; Kunes, J.; Buchta, V.; Vejsova, M.; Opletalova, V. Novel Pyrazine Analogs of Chalcones: Synthesis and Evaluation of Their Antifungal and Antimycobacterial Activity. Molecules 2015, 20, 1104–1117. [Google Scholar] [CrossRef] [PubMed]
- Su, F.; Su, Z.; Zhao, Q.; Zhao, Z.; Wu, Z.; Zhao, M.; Lai, M. Synthesis, Thermal Property and Antifungal Evaluation of Pyrazine Esters. Arab. J. Chem. 2022, 15, 104351. [Google Scholar] [CrossRef]
- Guazzotti, V.; Hendrich, V.; Gruner, A.; Störmer, A.; Welle, F. Styrene Monomer Levels in Polystyrene-Packed Dairy Products from the Market versus Simulated Migration Testing. Foods 2023, 12, 2609. [Google Scholar] [CrossRef]
- Kubica, D.; Kaczmarczyk, M.; Kaszuba, A. Determination of Volatile Organic Compounds in Materials from Polystyrene Intended for Contact with Food: Comparison of HS-GS/MS and SPME-GC/MS Techniques. Rocz. Panstw. Zakl. Hig. 2018, 69, 235–242. [Google Scholar]
- Pagot, Y.; Belin, J.-M.; Husson, F.; Spinnler, H.-E. Metabolism of Phenylalanine and Biosynthesis of Styrene in Penicillium Camemberti. J. Dairy Res. 2007, 74, 180–185. [Google Scholar] [CrossRef]
- Lafeuille, J.-L.; Buniak, M.-L.; Vioujas, M.-C.; Lefevre, S. Natural Formation of Styrene by Cinnamon Mold Flora. J. Food Sci. 2009, 74, M276–M283. [Google Scholar] [CrossRef]
Disclaimer/Publisher’s Note: The statements, opinions and data contained in all publications are solely those of the individual author(s) and contributor(s) and not of MDPI and/or the editor(s). MDPI and/or the editor(s) disclaim responsibility for any injury to people or property resulting from any ideas, methods, instructions or products referred to in the content. |
© 2025 by the authors. Licensee MDPI, Basel, Switzerland. This article is an open access article distributed under the terms and conditions of the Creative Commons Attribution (CC BY) license (https://creativecommons.org/licenses/by/4.0/).